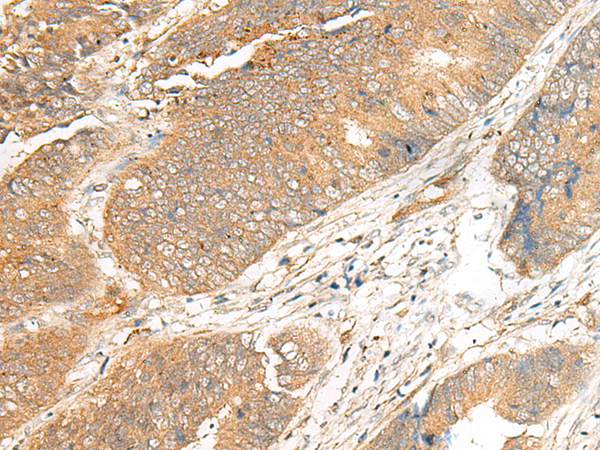

中文名稱: 兔抗ARHGEF18多克隆抗體
|
Background: |
Rho GTPases are GTP binding proteins that regulate a wide spectrum of cellular functions. These cellular processes include cytoskeletal rearrangements, gene transcription, cell growth and motility. Activation of Rho GTPases is under the direct control of guanine nucleotide exchange factors (GEFs). The protein encoded by this gene is a guanine nucleotide exchange factor and belongs to the Rho GTPase GFE family. Family members share a common feature, a Dbl (DH) homology domain followed by a pleckstrin (PH) homology domain. Alternatively spliced transcript variants encoding different isoforms have been identified. |
|
Applications: |
ELISA, IHC |
|
Name of antibody: |
ARHGEF18 |
|
Immunogen: |
Synthetic peptide of human ARHGEF18 |
|
Full name: |
Rho/Rac guanine nucleotide exchange factor 18 |
|
Synonyms: |
RP78; P114-RhoGEF |
|
SwissProt: |
Q6ZSZ5 |
|
ELISA Recommended dilution: |
5000-10000 |
|
IHC positive control: |
Human colorectal cancer and Human cervical cancer |
|
IHC Recommend dilution: |
25-100 |

購物車
購物車 幫助
幫助
 021-54845833/15800441009
021-54845833/15800441009
